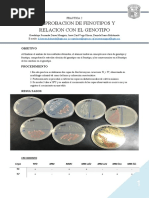

0% encontró este documento útil (0 votos)
1K vistas1 páginaGeotrichum SP
Geotrichum sp es un hongo ascomiceto que se encuentra como microbiota en humanos. Aunque rara vez causa infecciones en personas con sistemas inmunitarios saludables, puede provocar infecciones pulmonares oportunistas en personas severamente inmunosuprimidas. Se caracteriza por colonias de rápido crecimiento blancas y húmedas con hifas sumergidas en el medio y la formación de artroconidios hialinos de forma rectangular.
Cargado por
Estelly de los SantosDerechos de autor
© © All Rights Reserved
Nos tomamos en serio los derechos de los contenidos. Si sospechas que se trata de tu contenido, reclámalo aquí.
Formatos disponibles
Descarga como DOCX, PDF, TXT o lee en línea desde Scribd
0% encontró este documento útil (0 votos)
1K vistas1 páginaGeotrichum SP
Geotrichum sp es un hongo ascomiceto que se encuentra como microbiota en humanos. Aunque rara vez causa infecciones en personas con sistemas inmunitarios saludables, puede provocar infecciones pulmonares oportunistas en personas severamente inmunosuprimidas. Se caracteriza por colonias de rápido crecimiento blancas y húmedas con hifas sumergidas en el medio y la formación de artroconidios hialinos de forma rectangular.
Cargado por
Estelly de los SantosDerechos de autor
© © All Rights Reserved
Nos tomamos en serio los derechos de los contenidos. Si sospechas que se trata de tu contenido, reclámalo aquí.
Formatos disponibles
Descarga como DOCX, PDF, TXT o lee en línea desde Scribd